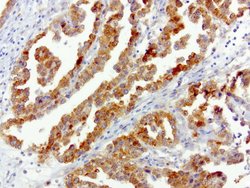
SQSTM1 Mouse anti-Human, Clone: UMAB13, liquid, UltraMAB 30 &mu;L | Buy Online | Origene Technologies | Fisher Scientific

missing translation for 'onlineSavingsMsg'
Learn More
Learn More
SQSTM1 Mouse anti-Human, Clone: UMAB13, liquid, UltraMAB™

Descripción
This gene encodes a multifunctional protein that binds ubiquitin and regulates activation of the nuclear factor kappa-B signaling pathway. The protein functions as a scaffolding/adaptor protein in concert with TNF receptor-associated factor 6 to mediate activation of NF-kB in response to upstream signals. Alternatively spliced transcript variants encoding either the same or different isoforms have been identified for this gene. Mutations in this gene result in sporadic and familial Paget disease of bone.
Especificaciones
Especificaciones
| Antígeno | SQSTM1 |
| Aplicaciones | Flow Cytometry, Immunocytochemistry, Immunofluorescence, Western Blot |
| Clasificación | Monoclonal |
| Clon | UMAB13 |
| Concentración | 0.5-1.0 mg/mL |
| Conjugado | Unconjugated |
| Formulación | PBS with 1% BSA, 50% glycerol and 0.02% sodium azide |
| génica | SQSTM1 |
| N.º de referencia del gen | Q13501 |
| Alias de gen | A170, DMRV, FTDALS3, NADGP, OSIL, PDB3, ZIP3, p60, p62, p62B |
| Mostrar más |
Título del producto
Al hacer clic en Enviar, acepta que Fisher Scientific se ponga en contacto con usted en relación con los comentarios que ha proporcionado en este formulario. No compartiremos su información para ningún otro fin. Toda la información de contacto proporcionada se mantendrá de acuerdo con nuestra Política de Privacidad. Política de privacidad.
¿Detecta una oportunidad de mejora?